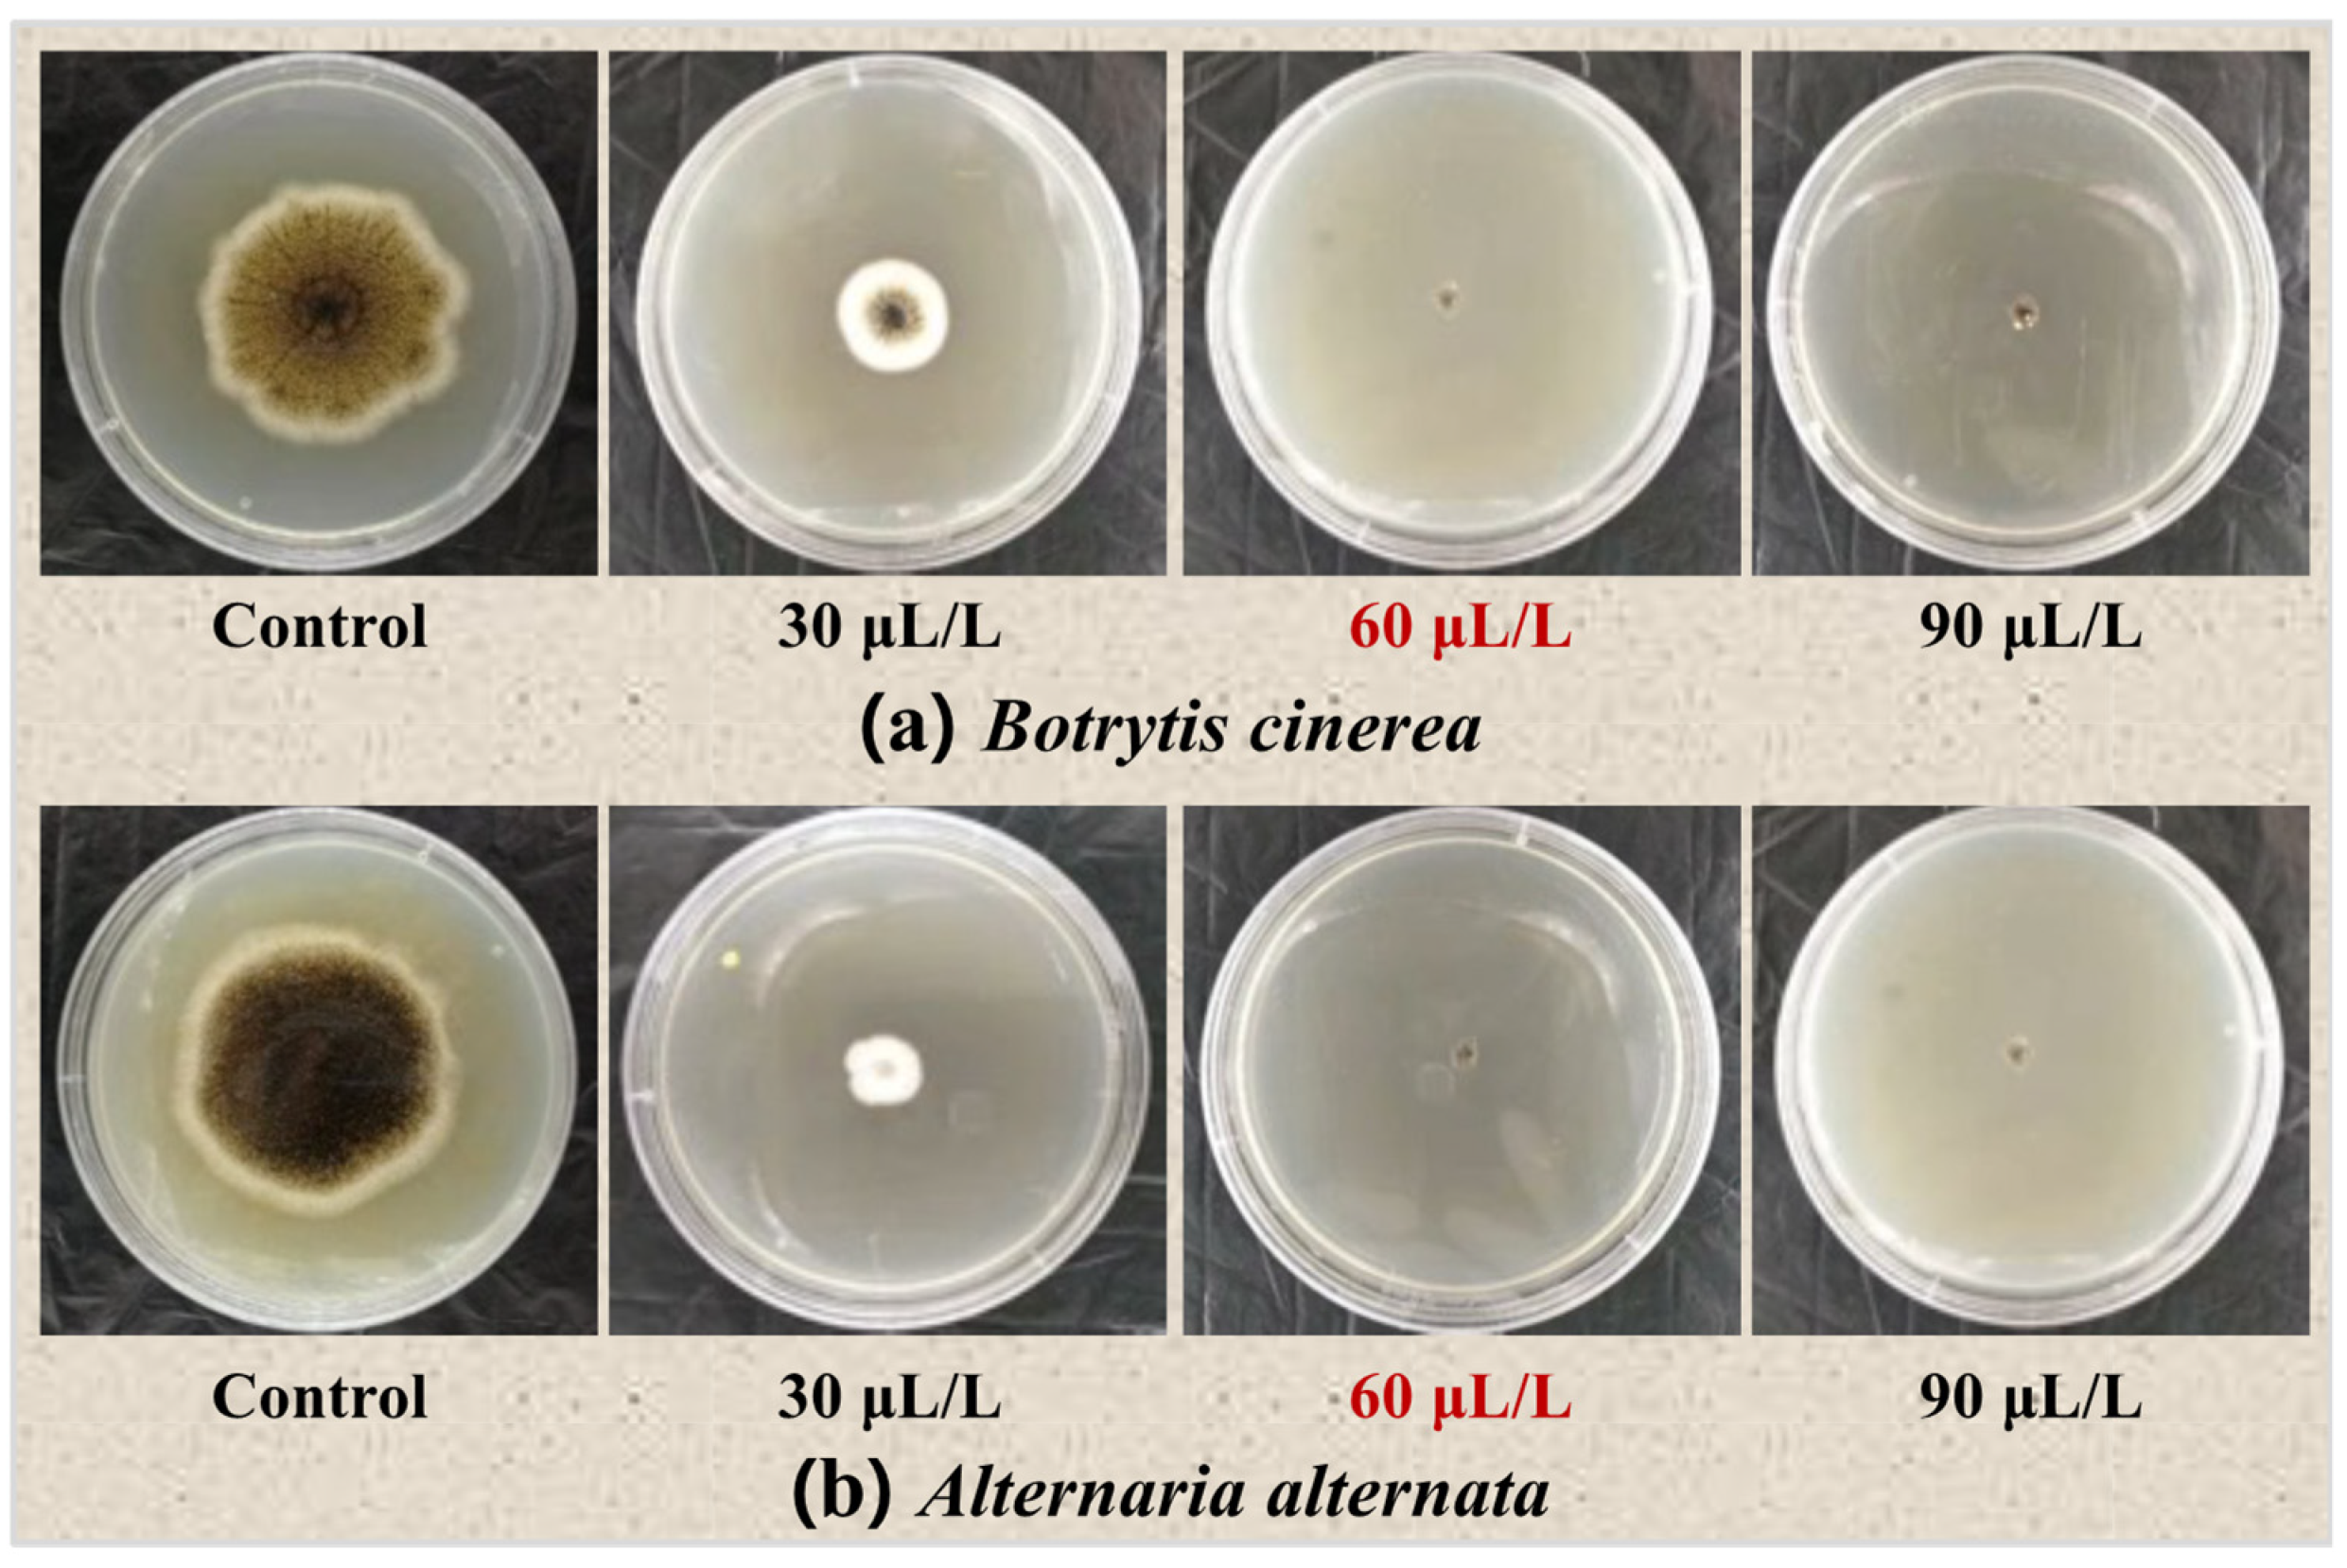
Horticulturae 10 00318 g003

Effects of Plant Essential Oil Treatment on the Growth of Pathogenic Fungi and the Activity of Defense-Related Enzymes of Fungi-Inoculated Blueberry
Abstract
1. Introduction
2. Materials and Methods
2.1. Materials
2.2. Screening of Plant Essential Oils
2.2.1. Preparation of Filter Paper Sheets
2.2.2. Preparation of Fungal Suspension
2.2.3. Selection of Essential Oils
2.3. Fungal Inhibition Experiment of Oregano Essential Oil
2.4. Fumigation Treatment of Oregano Essential Oil on Inoculated Blueberries
2.4.1. Blueberry Inoculation
2.4.2. Fumigation Treatment
2.5. Determination of Enzyme Activity Related to Disease Resistance
2.6. Statistical Analysis
3. Results and Discussion
3.1. Antifungal Activities of Six Plant Essential Oils in PDA Cultures
3.2. The Antifungal Effect of Oregano Essential Oil
3.3. Effect of Oregano Essential Oil on PAL Activity in Blueberry
3.4. Effect of Oregano Essential Oil on PPO Activity in Blueberry
3.5. Effect of Oregano Essential Oil on POD Activity in Blueberry
3.6. Effect of Oregano Essential Oil on CHI and GLU Activities in Blueberry
4. Conclusions
Author Contributions
Funding
Data Availability Statement
Conflicts of Interest
References
- Ji, Y.R.; Hu, W.Z.; Liao, J.; Xiu, Z.L.; Jiang, A.L.; Yang, X.Z.; Guan, Y.G.; Feng, K.; Saren, F. Effect of ethanol vapor treatment on the growth of Alternaria alternata and Botrytis cinerea and defense-related enzymes of fungi-inoculated blueberry during Storage. Front. Microbiol. 2021, 12, 618252. [Google Scholar] [CrossRef]
- Qin, S.W. Isolation, Identification, and Biological Control of Latent Pathogenic Fungi in Blueberry Fruits. Master’s Thesis, Dalian University of Technology, Dalian, China, 2017. [Google Scholar]
- Wang, C.Y.; Chen, C.T.; Yin, J.J. Effect of allyl isothiocyanate on antioxidants and fruit decay of blueberries. Food Chem. 2010, 120, 199–204. [Google Scholar] [CrossRef]
- Sommer, N.F. Role of controlled environments in suppression of postharvest diseases. Can. J. Plant Pathol. 1985, 7, 331–339. [Google Scholar] [CrossRef]
- Alessandra, R.; Camille, E.G.; Joséli, S. Optimization of Bacillus velezensis S26 sporulation for enhanced biocontrol of gray mold and anthracnose in postharvest strawberries. Postharvest Biol. Technol. 2024, 210, 112737. [Google Scholar]
- Wang, P.; Wu, T.; Cheng, Y.; Gao, Y.; Huang, B.; Li, Z. The phytocytokine systemin enhances postharvest tomato fruit resistance to Botrytis cinerea. Postharvest Biol. Technol. 2024, 210, 112774. [Google Scholar] [CrossRef]
- Xu, H.; Li, C.; Wang, M.; Guo, Y.; Zhang, S.; Ge, Y. Enhancement of disease resistance against Alternaria alternata in winter jujube fruit by phenyllactic acid through regulating Ca2+ signaling transduction and mitogen-activated protein kinase cascades. Postharvest Biol. Technol. 2024, 210, 112739. [Google Scholar] [CrossRef]
- Maringgal, B.; Hashim, N.; Tawakkal, I.S.M.A.; Moham, M.T.M. Recent advance in edible coating and its effect on fresh/fresh-cut fruits quality. Trends Food Sci. Technol. 2019, 96, 253–267. [Google Scholar] [CrossRef]
- Zanetti, M.; Carniel, T.K.; Dalcanton, F.; Anjos, R.S.D.; Riella, H.G.; Araújo, P.H.H.D.; Oliveira, D.D.; Fiori, M.A. Use of encapsulated natural compounds as antimicrobial additives in food packaging: A brief review. Trends Food Sci. Technol. 2018, 81, 51–60. [Google Scholar] [CrossRef]
- Marta, M.; Silvia, B.; Dharini, S. Decay control in the postharvest system: Role of microbial and plant volatile organic compounds. Postharvest Biol. Technol. 2016, 122, 70–81. [Google Scholar]
- Jugreet, B.S.; Suroowan, S.; Rengasamy, R.R.K.; Mahomoodally, M.F. Chemistry, bioactivities, mode of action and industrial applications of essential oils. Trends Food Sci. Technol. 2020, 101, 89–105. [Google Scholar] [CrossRef]
- Zhou, X.; Wang, J.; Gu, N.; Zheng, Y. Research progress on the preservative and fresh-keeping effects of plant essential oils on fruits and vegetables. Food Sci. 2010, 31, 427–430. [Google Scholar]
- Prakash, B.; Kedia, A.; Mishra, P.K.; Dubey, N.K. Plant essential oils as food preservatives to control moulds, mycotoxin contamination and oxidative deterioration of agri-food commodities—Potentials and challenges. Food Control 2015, 47, 381–391. [Google Scholar] [CrossRef]
- Arasu, M.V.; Viayaraghavan, P.; Ilavenil, S.; Al-Dhabi, N.A.; Choi, K.C. Essential oil of four medicinal plants and protective properties in plum fruits against the spoilage bacteria and fungi. Ind. Crops Prod. 2019, 133, 54–62. [Google Scholar] [CrossRef]
- Jahani, M.; Pira, M.; Aminifard, M.H. Antifungal effects of essential oils against Aspergillus niger in vitro and in vivo on pomegranate (Punica granatum) fruits. Sci. Hortic. 2020, 264, 109188. [Google Scholar] [CrossRef]
- Lin, S.; Wang, W.; Zhang, J.; Yang, X. Preliminary screening of in vitro antibacterial activity of 10 plant essential oils against blueberry pathogens. Hunan Agric. Sci. 2018, 2, 73–75. [Google Scholar]
- Cindi, M.D.; Soundy, P.; Romanazzi, G.; Sivakumar, D. Different defense responses and brown rot control in two Prunus persica cultivars to essential oil vapours after storage. Postharvest Biol. Technol. 2016, 119, 9–17. [Google Scholar] [CrossRef]
- Pan, L.Y.; Zhao, X.Y.; Chen, M.; FU, Y.Q.; Xiang, M.L.; Chen, J.Y. Methyl jasmonate regulates defense enzyme activity and induces resistance to postharvest soft rot disease in kiwifruit. Plant Prot. 2019, 45, 75–80. [Google Scholar]
- Wei, Y.; Wei, Y.; Xu, F.; Shao, X. The combined effects of tea tree oil and hot air treatment on the quality and sensory characteristics and decay of strawberry. Postharvest Biol. Technol. 2018, 136, 139–144. [Google Scholar] [CrossRef]
- Gemma, O.; Ma, A.R.G.; Laura, A.G.; Paula, V.; Robert, S.F.; Ma, I.H.H.; Isabel, P.M.; Susana, F. Recent approaches using chemical treatments to preserve quality of fresh-cut fruit: A review. Postharvest Biol. Technol. 2010, 57, 139–148. [Google Scholar]
- Carlos, D.G.; Clemencia, C.; Annalisa, S.; Chiara, R.; Antonello, P. Chitosan coatings enriched with essential oils: Effects on fungi involved in fruit decay and mechanisms of action. Trends Food Sci. Technol. 2018, 78, 61–71. [Google Scholar]
- Shao, X.; Wang, H.; Xu, F.; Cheng, S. Effects and possible mechanisms of tea tree oil vapor treatment on the main disease in postharvest strawberry fruit. Postharvest Biol. Technol. 2013, 77, 94–101. [Google Scholar] [CrossRef]
- Liu, H.X. The Regulatory Effects of 1-MCP, BTH, and PHC on Postharvest Senescence of Peach Fruit (Prunus persica L.) and Their Induced Disease Resistance Mechanisms. Ph.D. Thesis, China Agricultural University, Beijing, China, 2004. [Google Scholar]
- Ozturk, A.; Yildiz, K.; Ozturk, B.; Karakaya, O.; Gun, S.; Uzun, S.; Gundogdu, M. Maintaining postharvest quality of medlar (Mespilus germanica) fruit using modified atmosphere packaging and methyl jasmonate. LWT-Food Sci. Technol. 2019, 111, 117–124. [Google Scholar] [CrossRef]
- Gao, Y.; Kan, C.; Wan, C.; Chen, C.; Chen, M.; Chen, J. Quality and biochemical changes of navel orange fruits during storage as affected by cinnamaldehyde-chitosan coating. Sci. Hortic. 2018, 239, 80–86. [Google Scholar] [CrossRef]
- Xu, H.X. A Study on the Effects and Mechanisms of Different Silicon Source Preparations on the Main Post Harvest Diseases of Grapes. Master’s Thesis, Gansu Agricultural University, Lanzhou, China, 2004. [Google Scholar]
- He, C.; Zhang, Z.; Li, B.; Xu, Y.; Tian, S. Effect of natamycin on Botrytis cinerea and Penicillium expansum—Postharvest pathogens of grape berries and jujube fruit. Postharvest Biol. Technol. 2019, 151, 134–141. [Google Scholar] [CrossRef]
- Bill, M.; Sivakumar, D.; Beukes, M.; Korsten, L. Expression of pathogenesis-related (PR) genes in avocados fumigated with thyme oil vapours and control of anthracnose. Food Chem. 2016, 194, 938–943. [Google Scholar] [CrossRef]

| Fungal Species | Oregano Essential Oil Concentration (μL/L) | |||
| 0 | 30 | 60 | 90 | |
| Botrytis cinerea | ++ | + | − | − |
| Alternaria alternata | ++ | + | − | − |
Disclaimer/Publisher’s Note: The statements, opinions and data contained in all publications are solely those of the individual author(s) and contributor(s) and not of MDPI and/or the editor(s). MDPI and/or the editor(s) disclaim responsibility for any injury to people or property resulting from any ideas, methods, instructions or products referred to in the content. |
© 2024 by the authors. Licensee MDPI, Basel, Switzerland. This article is an open access article distributed under the terms and conditions of the Creative Commons Attribution (CC BY) license (https://creativecommons.org/licenses/by/4.0/).
Share and Cite
Ji, Y.; Hu, W.; Guan, Y.; Saren, G. Effects of Plant Essential Oil Treatment on the Growth of Pathogenic Fungi and the Activity of Defense-Related Enzymes of Fungi-Inoculated Blueberry. Horticulturae 2024, 10, 318. https://doi.org/10.3390/horticulturae10040318
Ji Y, Hu W, Guan Y, Saren G. Effects of Plant Essential Oil Treatment on the Growth of Pathogenic Fungi and the Activity of Defense-Related Enzymes of Fungi-Inoculated Blueberry. Horticulturae. 2024; 10(4):318. https://doi.org/10.3390/horticulturae10040318
Chicago/Turabian StyleJi, Yaru, Wenzhong Hu, Yuge Guan, and Gaowa Saren. 2024. "Effects of Plant Essential Oil Treatment on the Growth of Pathogenic Fungi and the Activity of Defense-Related Enzymes of Fungi-Inoculated Blueberry" Horticulturae 10, no. 4: 318. https://doi.org/10.3390/horticulturae10040318
APA StyleJi, Y., Hu, W., Guan, Y., & Saren, G. (2024). Effects of Plant Essential Oil Treatment on the Growth of Pathogenic Fungi and the Activity of Defense-Related Enzymes of Fungi-Inoculated Blueberry. Horticulturae, 10(4), 318. https://doi.org/10.3390/horticulturae10040318
